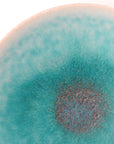
绿松石圆小碟

绿松石圆小碟
配送料
沖縄県を除く全国一律:1,100円(沖縄県:3,300円)
产地:京都
尺寸:9×Φh2cm
清爽的蓝绿色宛如闪闪发光的大海。
佐料和山珍海味等。
每一幅的釉的流向和浓淡也不同,表情的差异也很有趣。
写真内のその他のうつわ
よくある質問
A.器の購入後はして頂きたい作業がございます。これをして頂くことで長くお使い頂けます。
【購入したらやること】
器には大きく分けて陶器と磁器のふたつがあります。簡単に言うと陶器は土、磁器は石を原料としています。土である陶器は吸水性があるため、水分や油分が染み込むと臭いやカビの原因となります。
陶器をお買い求めいただいたら、まず〈目止め〉をしてください。
目止めとは、陶器に無数にある小さな穴の表面をコーティングし、染みや汚れをある程度防ぐことができます。
鍋に米の研ぎ汁(もしくは小麦粉や片栗粉を入れた水)を器が隠れる程度入れ、中火でゆっくり温度を上げていきます。沸騰する手前で弱火にし、10分ほどしたら火を止め、そのまま半日ほど鍋が自然に冷めるまで置いておきます。
※火加減が強すぎると器の一部だけが高温となり、ヒビや割れなど破損する場合があります。
※急な冷却は器の破損につながります。
※複数の器を一度に目止めする場合は、器同士が直接ぶつからないよう器の間にキッチンペーパーなどを挟みます。
目止めをすることで、デンプン質が器の細かな間に入り、汚れが入り込むのを防ぎます
A.当店で扱っている器は作家、職人が一つひとつ手仕事で丁寧に作っています。 現代の生活には欠かせない電子レンジや食器洗浄機など、使用できないものもあることを御了承ください。
電子レンジ
基本的にあたため程度での使用であれば問題ない場合が多いですが、急激な温度変化は破損の原因になります。 但し、金彩や銀彩など金属の装飾を施したものは、火花が出ることがあるので使用しないでください。
食器洗浄機
電子レンジ同様に金属での装飾を施したものは剥がれる可能性があります。 食器洗浄機は水量の多いため、吸水性がある陶器は染み込みやすくなります。 染み込んだまま庫内の湿度や温度にさらされることで、臭いやカビの原因になります。 また、近くの器と庫内でぶつかることで破損の原因となる場合があります。
少し不便に感じるところもあるかもしれません。
しかし、お気に入りの器だからこそ、作り手が手間を惜しまず作ったように、大切に扱っていただけたらと思います。
使っていくうちに少しずつ色味が落ち着いてきたり、多少の傷や染みがつくこともあるでしょう。 私たちはそれを〈景色〉と呼んでいます。 そんな景色の変化を楽しみ、自分だけの器に育てていただければ幸いです。
A.各種支払い方法がご利用いただけます。
・支払方法
クレジットカード決済、翌月後払い、PayPal、銀行振込、楽天ペイがご利用頂けます。
・クレジットカード決済、PayPal、キャリア決済、楽天ペイ
商品注文時点でお支払いが確定いたします。
・翌月後払い
Paidyを通し、1ヶ月分のご利用額をまとめて、翌月10日までにコンビニや銀行振込でお支払いをお願いいたします。
A.原則としてキャンセルは受け付けておりません。
お荷物の出荷後、⻑期不在や受取拒否などにより、お荷物がお受け取り頂けず返品扱いになってしまった場合、今後ご注文をお断りさせて頂く場合がございます。予めご了承頂けますようお願い申し上げます。